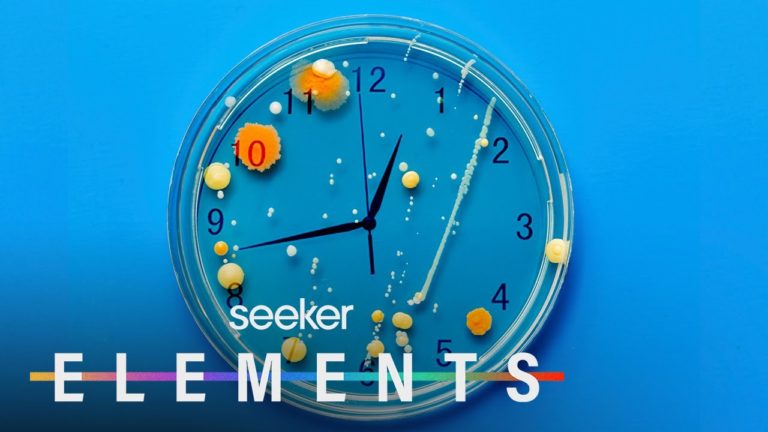

Bacteria Can Tell Time…Wait, What?!
Humans, animals, and plants have a biological clock—and turns out, bacteria do too! If we can better understand how exactly the microorganisms tick, there could be incredible implications for medicine, agriculture, and more.
This concept of a biological clock is often called a circadian rhythm. You may think of it just as those signals that make you sleepy at night and wake your body in the morning, but there are actually thousands of tiny clocks, controlling all kinds of biological pathways inside of us on timed cycles.
They’re this beautiful, finely tuned dance of sensory information coming in, sparking a cascade of hormones and other signaling chemicals, turning the cogs of some very specific molecular machinery in our cells.
In humans, they’re important to our health and mental processing, and in animals that have them, biological clocks help us adapt our behavior to our environment. So, I guess it’s not surprising that we see these rhythms in plants, too.
But what’s a little weirder is that just regular old bacteria, chilling in the soil or on our bodies or in your fridge…also have an internal clock! Now, you might be saying, ok that’s interesting, but like…why should we really care? And I see where you’re coming from, but bacteria are EVERYWHERE.
We can’t even see them with our naked eye and yet they make up roughly 15% of all the biomass on this planet. They are essential not only to human health, but to the health of the crops we grow and to the creation of industrial products.
Do not forget to share your opinion with us to provide you with the best posts !
0 Comments